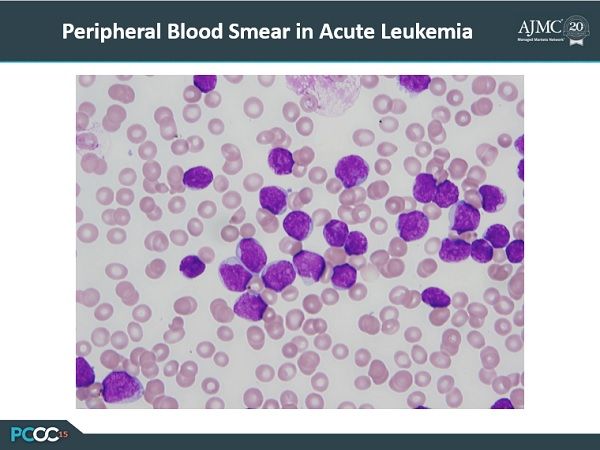

Joseph AlvarÂnas, MD, direcÂtor of value-based analytics at City of Hope, Duarte, California, and editor-in-chief of Evidence-Based Oncology painted an upbeat picture of cancer cure rates at the 2015 meeting of Patient-Centered Oncology Care.
Joseph Alvar­nas, MD, direc­tor of value-based analytics at City of Hope, Duarte, California, and editor-in-chief of Evidence-Based Oncology painted an upbeat picture of cancer cure rates at the 2015 meeting of Patient-Centered Oncology Care.
During his session, Dr Alvarnas outlined the rapid changes in medicine and the profound impact the development of targeted immunotherapy agents have had on patient outcomes. Here are the slides from his session, slightly modified.

Exploring Racial, Ethnic Disparities in Cancer Care Prior Authorization Decisions
October 24th 2024On this episode of Managed Care Cast, we're talking with the author of a study published in the October 2024 issue of The American Journal of Managed Care® that explored prior authorization decisions in cancer care by race and ethnicity for commercially insured patients.
Listen